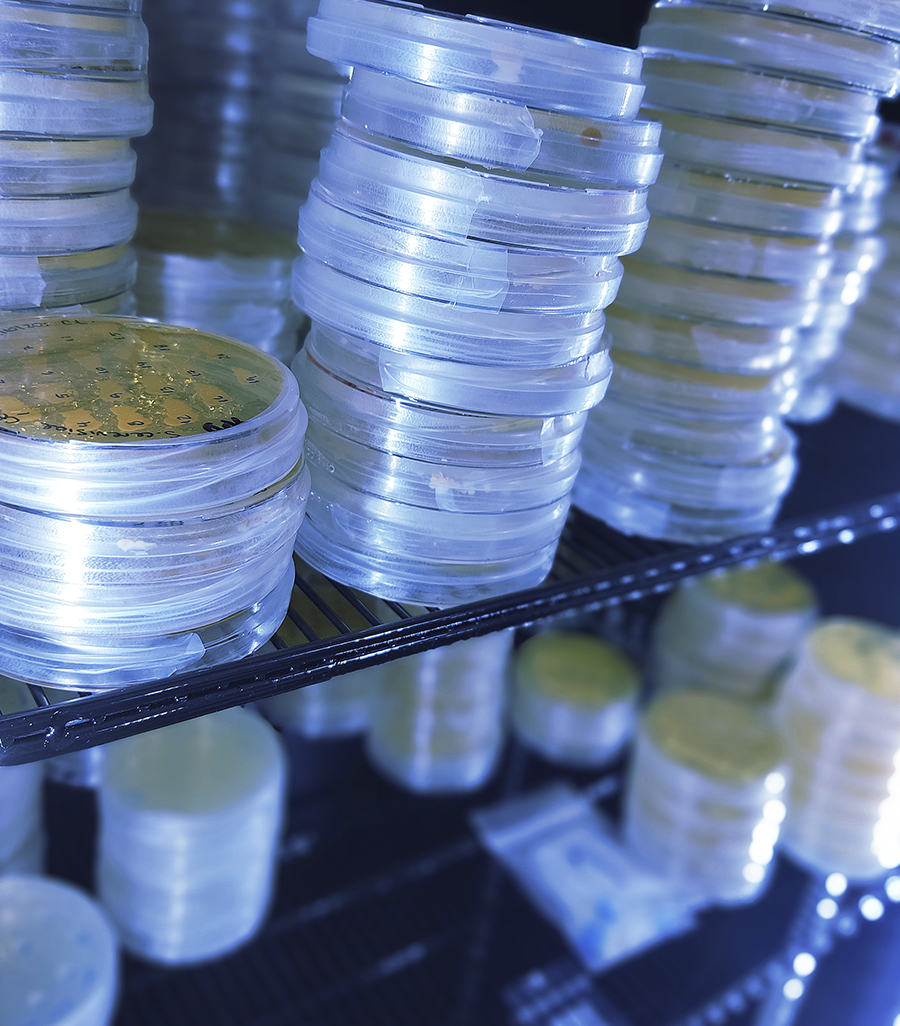

We are Merken Biotech
We bring together creative minds, infrastructure and the highest level team to develop quality science.
We are a Contract Research Organization that provides R&D and Innovation services from Chile to the world.
Throughout the years we have specialized in the areas of biomedicine and biotechnology.
Our comprehensive services allow us to accompany you in each of your projects, creating and transforming ideas into products with a positive impact for our society.


We are a biotech company with a large experience in R&D
0
+
Projects
0
+
Clients
0
+
Professionals in the team
0
+
Patent invention collaborator
0
+
Research Areas
Capabilities and Technology

Our team has extensive experience in the development and use of various molecular biology tools.
Some of our capabilities are:
Primer design...
Learn More
Molecular Biology

We can offer live cell-based assays of biologically relevant models that can be used to follow:
Dynamic variables.
Functional or biochemical effects...
Learn More
Cell Biology
Our specialists have vast experience in developments in the microbiological area.
We have facilities and equipment that allow us to:
Develop processes...
Learn More
Microbiology

Understanding the pharmacokinetics (PK) and pharmacodynamics (PD) of your test compounds (e.g. small or large molecules, antibodies and even nucleic...
Learn More
Pharmacology

Merken's histology service has professionals with decades of experience to provide high quality histology services in a wide range of...
Learn More
Histology & Immunochemistry

Our team can support the development of customized assays to answer your immunological questions.
We have experience working with:
Human and mouse...
Learn More
Immunology

Our team of engineers is trained and ready to provide you with effective and efficient solutions for the development of...
Learn More
Bioprocess

Our team has vast experience in the field of qualification / quantification of new molecules. With us, you will be...
Learn More
Liquid Chromatography and Mass Spectrometry
In each area we will guide you through every stage of your project
Let’s talk!
Write to us if you require more information about our company or any other requirement.
Let’s talk!
Write to us if you require more information about our company or any other requirement.












